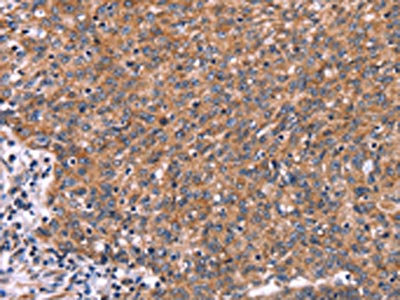

HACE1 Antibody
-
中文名稱:HACE1兔多克隆抗體
-
貨號:CSB-PA223356
-
規格:¥1100
-
圖片:
-
The image on the left is immunohistochemistry of paraffin-embedded Human colon cancer tissue using CSB-PA223356(HACE1 Antibody) at dilution 1/50, on the right is treated with synthetic peptide. (Original magnification: ×200)
-
The image on the left is immunohistochemistry of paraffin-embedded Human ovarian cancer tissue using CSB-PA223356(HACE1 Antibody) at dilution 1/50, on the right is treated with synthetic peptide. (Original magnification: ×200)
-
-
其他:
產品詳情
-
Uniprot No.:
-
基因名:HACE1
-
別名:HACE1 antibody; KIAA1320E3 ubiquitin-protein ligase HACE1 antibody; EC 2.3.2.26 antibody; HECT domain and ankyrin repeat-containing E3 ubiquitin-protein ligase 1 antibody; HECT-type E3 ubiquitin transferase HACE1 antibody
-
宿主:Rabbit
-
反應種屬:Human,Mouse,Rat
-
免疫原:Synthetic peptide of Human HACE1
-
免疫原種屬:Homo sapiens (Human)
-
標記方式:Non-conjugated
-
抗體亞型:IgG
-
純化方式:Antigen affinity purification
-
濃度:It differs from different batches. Please contact us to confirm it.
-
保存緩沖液:-20°C, pH7.4 PBS, 0.05% NaN3, 40% Glycerol
-
產品提供形式:Liquid
-
應用范圍:ELISA,IHC
-
推薦稀釋比:
Application Recommended Dilution ELISA 1:2000-1:5000 IHC 1:100-1:200 -
Protocols:
-
儲存條件:Upon receipt, store at -20°C or -80°C. Avoid repeated freeze.
-
貨期:Basically, we can dispatch the products out in 1-3 working days after receiving your orders. Delivery time maybe differs from different purchasing way or location, please kindly consult your local distributors for specific delivery time.
-
用途:For Research Use Only. Not for use in diagnostic or therapeutic procedures.
相關產品
靶點詳情
-
功能:E3 ubiquitin-protein ligase involved in Golgi membrane fusion and regulation of small GTPases. Acts as a regulator of Golgi membrane dynamics during the cell cycle: recruited to Golgi membrane by Rab proteins and regulates postmitotic Golgi membrane fusion. Acts by mediating ubiquitination during mitotic Golgi disassembly, ubiquitination serving as a signal for Golgi reassembly later, after cell division. Specifically interacts with GTP-bound RAC1, mediating ubiquitination and subsequent degradation of active RAC1, thereby playing a role in host defense against pathogens. May also act as a transcription regulator via its interaction with RARB.
-
基因功能參考文獻:
- A functional interplay between HACE1 and Rac1 in cancer, is reported. PMID: 28317937
- Results identified HACE1 Ser-385 as a pivotal amino acid residue that is phosphorylated in response to CNF1 or VEGF treatments and that expression of activated Rac1 is sufficient to induce HACE1 phosphorylation and controlling its oligomerization state. PMID: 29362425
- Results indicated that HACE1 rs9404576 polymorphism may be associated with Wilms' tumor susceptibility in the Chinese population. PMID: 29243987
- 3-deazaneplanocin A treatment increased HACE1 gene expression which was further increased by the addition of trichostatine A (TSA), a promising therapeutic compound for the treatment of human B-Lymphoma PMID: 28651105
- HACE1 can act as a haploinsufficient tumor suppressor gene in most B-cell lymphomas and can be downregulated by deacetylation of its promoter region chromatin PMID: 27107267
- Hepatocellular carcinoma patients with low HACE1 expression levels exhibited poorer overall survival and HACE1 was found to be an independent prognostic factor for survival. PMID: 27805249
- HACE1 as a specific E3 ligase that polyubiquitinates YB-1 through non-canonical K27 linked ubiquitin chains. PMID: 26343856
- Biallelic loss-of-function mutations in HACE1 are associated with an autosomal recessive neurodevelopmental syndrome. PMID: 26424145
- supports a critical role for HACE1 in breast cancer progression and identifies patients that may benefit from Rac-targeted therapies PMID: 25659579
- contrary to previous report, overexpression of HACE1 by transduction of recombinant protein did not affect proliferation or survival of NKTCL cell lines. We therefore conclude that HACE1 is not directly involved in NKTCL pathophysiology PMID: 25203537
- HACE1-OPTN axis synergistically suppresses growth and tumorigenicity of lung cancer cells. PMID: 25026213
- Ubiquitylation and activation of RAB11a is promoted by a beta2 adrenergic receptor-HACE1 complex. PMID: 24190883
- HACE1 reduces oxidative stress and mutant Huntingtin toxicity by promoting the NRF2 response. PMID: 24516159
- All stages of HCCs presented HACE1 methylation, indicating that the HACE1 gene has been methylated from the early stages of HCCs. PMID: 23732777
- HACE1 is tumor suppressor gene located within the 6q21 region, and loss of function of multiple tumor suppressor genes within 6q21 may be a critical determinant of NK cell lymphomagenesis. PMID: 23142381
- HACE1 is an antagonist of cell migration through its ability to degrade active Rac1. PMID: 22614015
- common variants in HACE1 and LIN28B influence neuroblastoma susceptibility and indicate that both genes likely have a role in disease progression. PMID: 22941191
- The HACE1 expression increases the ubiquitylation of Rac1, when the GTPase is activated by point mutations or by the GEF-domain of Dbl. PMID: 22036506
- The 6q21-22 region was confirmed as a celiac disease susceptibility locus and harbors multiple independent associations, some of which may implicate ubiquitin-pathways in celiac disease susceptibility, such as mutations in gene HACE1. PMID: 21326284
- Deregulation of the tumor suppressor HACE1 is associated with natural killer/T-cell lymphoma, nasal type. PMID: 19965620
- Hace1 as a novel ubiquitin-protein ligase with very low expression Wilms' tumors; hypermethylation of two upstream CpG islands correlates with low HACE1 expression in tumor samples. PMID: 15254018
- HACE1 is a candidate chromosome 6q21 tumor-suppressor gene involved in multiple cancers. PMID: 17694067
- Aberrant methylation of the HACE1 gene was detected in 9 out of the 32 (28%) primary colon carcinomas. PMID: 18630515
- Aberrant methylation of the HACE1 gene is associated with gastric carcinoma. PMID: 19528486
顯示更多
收起更多
-
相關疾病:Spastic paraplegia and psychomotor retardation with or without seizures (SPPRS)
-
亞細胞定位:Golgi apparatus, Golgi stack membrane. Cytoplasm. Endoplasmic reticulum. Note=A significant portion localizes to the endoplasmic reticulum. Targeted to Golgi membrane via its interaction with Rab proteins.
-
組織特異性:Expressed in multiple tissues including heart, brain and kidney.
-
數據庫鏈接: